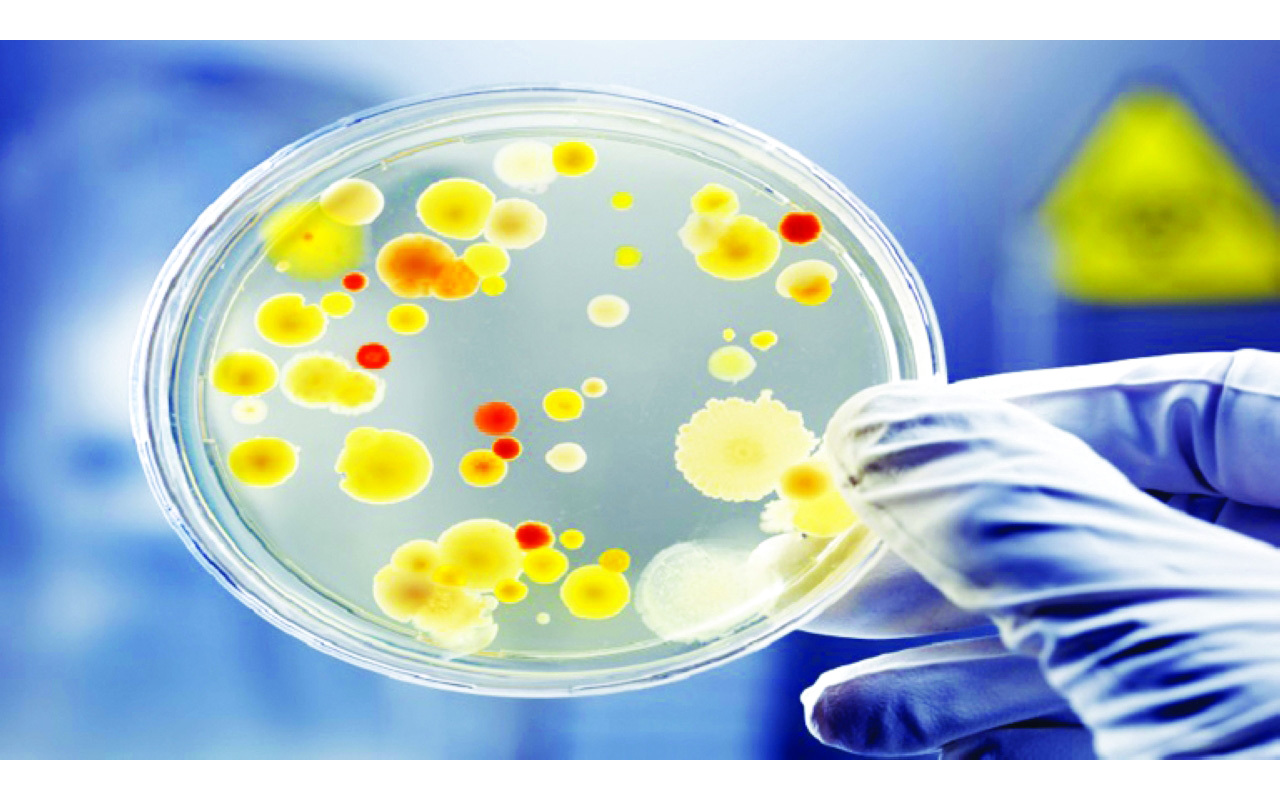

طور فريق من المهندسين الكيميائيين في المعهد الكوري المتقدم للعلوم والتكنولوجيا نظاماً من جزأين لتحويل ثاني أكسيد الكربون إلى نوع شائع من البلاستيك الحيوي بمساعدة نوع بكتيري يسمى «كوبريافيدوس نيكيتور».
وذلك عن طريق المحلل الكهربائي الذي يحول غاز ثاني أكسيد الكربون إلى فورمات. ثم يتم إدخالها في خزان التخمير، حيث تعمل البكتيريا.
ويشتهر هذا النوع من البكتيريا بقدرته على تصنيع أنواع من مركبات الكربون، وهي نوع من البوليستر القابل للتحلل الحيوي والسماد، من مصادر الكربون الأخرى. وفي هذه الحالة، تلتهم هذه البكتيريا المادة الخام للفورمات.